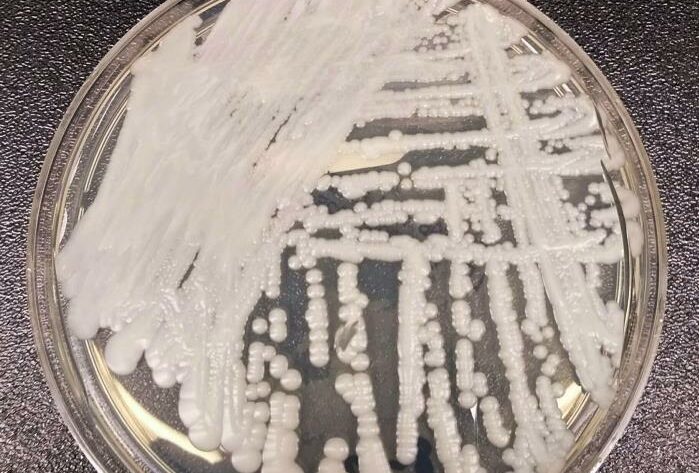

A Agência Nacional de Vigilância Sanitária (Anvisa) informou, nesta quarta-feira (12), que foi confirmado o terceiro surto nacional do fungo Candida auris, conhecido por ser resistente a praticamente todos os medicamentos existentes. O caso que iniciou o novo surto do chamado “superfungo” foi registrado em um hospital da rede pública do Recife, em Pernambuco.
De acordo com a agência, apesar de, no momento, haver só um caso confirmado e outro em análise no Brasil, a determinação de que há um surto de Candida auris no país ocorre porque a definição epidemiológica de surto não envolve apenas um grande número de casos de doenças contagiosas, mas também outros fatores.
“[O surto] abrange não apenas uma grande quantidade de casos de doenças contagiosas ou de ordem sanitária, mas também o surgimento de um microrganismo novo na epidemiologia de um país ou até de um serviço de saúde, mesmo se for apenas um caso”, ressaltou a Anvisa, em nota.
A agência disse ainda que já orientou que os laboratórios de microbiologia intensifiquem a vigilância laboratorial para a identificação do fungo Candida auris e pediu que, diante de qualquer caso suspeito, os laboratórios informem imediatamente a Comissão de Controle de Infecção Hospitalar (CCIH) do serviço de saúde.
Informações: Pleno News